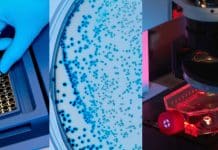
Genelon invites for Short-term custom-based Workshops with Specialised courses | Enroll Now

Genelon invites for Short-term custom-based Workshops with Specialised courses | Enroll Now
Genelon invites for Short-term custom-based Workshops with Specialised courses | Enroll Now
Genelon is embarked on imparting industrial-oriented training programs in a wide range of...
Short Term Training on Immunology and Bioinformatics @ IIAR, Gandhinagar
Short Term Training on Immunology and Bioinformatics @ IIAR, Gandhinagar
Located on the banks of river Sabarmati, Gujarat, the land of Mahatma Gandhi, Institute of...
Bubble Technology can now deliver drugs directly to tumors
Bubble Technology can now deliver drugs directly to tumors
According to the findings published in the Journal Asia Materials, cancer drugs can be delivered deep...
Tumor cells march one by one in narrow vessels!
Tumor cells march one by one in narrow vessels!
Metastasis is responsible for 90% of cancer-related deaths and is driven by tumor cells circulating in...
NCTU Taiwan Internship Program | Scholarship of NTD 5,000 including tax
NCTU Taiwan Internship Program | Scholarship of NTD 5,000 including tax
National Chiao Tung University is a top research university in Taiwan located adjacent to...
Mundo Sano, Protein Sciences and Sinergium Team up to Develop Zika Vaccine
Mundo Sano, Protein Sciences and Sinergium Team up to Develop Zika Vaccine
Protein Sciences, Sinergium Biotech, and the private foundation Mundo Sano said today they...
Stem Cell Therapies Could be Undermined by Flawed Mitochondrial DNA
Stem Cell Therapies Could be Undermined by Flawed Mitochondrial DNA
Mutations in our mitochondrial DNA tend to be inconspicuous, but they can become more prevalent as...
Is Fog Harvesting A Solution To Water Crisis?
Is Fog Harvesting A Solution To Water Crisis?
Water- Google it and you will get that it is made up of two hydrogen atoms and...
People-Centric Science – Harsh Vardhan Advocates Scientific Benefits for Common Man
Minister for Science and Earth Sciences Harsh Vardhan said the approach of science has to be people-centric and the common man should not remain...
British Drug Developer Forges Another Antibody Alliance this Year
British Drug Developer Forges Another Antibody Alliance this Year
British drug developer Heptares Therapeutics and mAb maker Kymab Ltd have partnered up in yet another...
Land Shark – Research Suggests Human Limbs may have Evolved from Sharks’ Gills
Land Shark - Research Suggests Human Limbs may have Evolved from Sharks' Gills
Human limbs share a genetic programme with the respiratory organs of fishes...
New Study Says Greenery Around Home Increases Women’s Life Span
New Study Says Greenery Around Home Increases Women's Life Span
Women live longer in areas with more green vegetation, according to new research funded by...
New Study may give way for Monocyte-based cell Therapy
New Study may give way for Monocyte-based cell Therapy
Researchers from VIB-UGent reveal that adult circulating monocytes that get access to the macrophage niche in...
Scientists develop New Mouse model to enhance research of Zika virus
Scientists develop New Mouse model to enhance research of Zika virus
Researchers at the University of Wisconsin-Madison School of Veterinary Medicine (SVM) have developed one...
ISRO’s Spin-off : From Space Technology to BioTecnology
ISRO's Spin-off : From Space Technology to BioTecnology
The Indian Space Research Organization (ISRO) has taken a step back from space technology and thrived its...